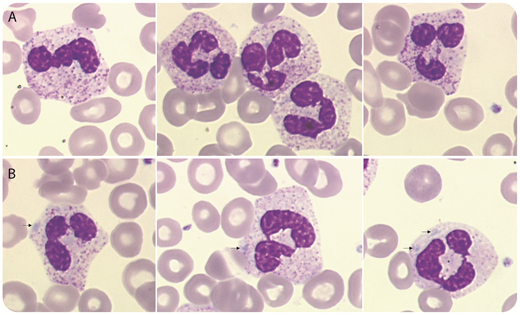
A 69-year-old man was referred for unexplained leukocytosis, discovered 4 months earlier. Clinical examination revealed splenomegaly, and C-reactive protein was normal. The blood count showed anemia (hemoglobin, 96 g/L) and confirmed leukocytosis (white blood cell count, 81 × 109/L), with 69.7 × 109/L (relative value 86%) neutrophils. Toxic granulations (panel A; original magnification ×1000, May-Grünwald-Giemsa stain) and Döhle bodies (arrows, panel B; original magnification ×1000, May-Grünwald-Giemsa stain), commonly found in reactive conditions, were observed. Some neutrophil precursors (5.7 × 109/L, relative value 7%) and a slight monocytosis (1.6 × 109/L, relative value 2%) were present, but no basophils were observed. BCR-ABL1 fusion gene and JAK2, CALR, and MPL mutations were absent. Next-generation sequencing revealed CSF3R T618I, SETBP1 D868N, and ASXL1 L775X mutations. These results converged to point to a diagnosis of chronic neutrophilic leukemia (CNL). / CNL is a rare Philadelphia-negative myeloproliferative neoplasm whose true incidence is unknown. The close association between activating mutations of the CSF3R gene and CNL has recently refined its diagnosis. Therefore, with regard to >200 previously described cases, only some would meet current diagnostic criteria. This is particularly useful for differentiating CNL from neutrophil leukemoid reaction, secondary to other diseases (multiple myeloma or monoclonal gammopathy of undetermined significance, in particular). CNL is considered a slowly progressing disease, but survival varies greatly. The coexistence of an ASXL1 mutation may be associated with a poorer prognosis.

A 69-year-old man was referred for unexplained leukocytosis, discovered 4 months earlier. Clinical examination revealed splenomegaly, and C-reactive protein was normal. The blood count showed anemia (hemoglobin, 96 g/L) and confirmed leukocytosis (white blood cell count, 81 × 109/L), with 69.7 × 109/L (relative value 86%) neutrophils. Toxic granulations (panel A; original magnification ×1000, May-Grünwald-Giemsa stain) and Döhle bodies (arrows, panel B; original magnification ×1000, May-Grünwald-Giemsa stain), commonly found in reactive conditions, were observed. Some neutrophil precursors (5.7 × 109/L, relative value 7%) and a slight monocytosis (1.6 × 109/L, relative value 2%) were present, but no basophils were observed. BCR-ABL1 fusion gene and JAK2, CALR, and MPL mutations were absent. Next-generation sequencing revealed CSF3R T618I, SETBP1 D868N, and ASXL1 L775X mutations. These results converged to point to a diagnosis of chronic neutrophilic leukemia (CNL).
CNL is a rare Philadelphia-negative myeloproliferative neoplasm whose true incidence is unknown. The close association between activating mutations of the CSF3R gene and CNL has recently refined its diagnosis. Therefore, with regard to >200 previously described cases, only some would meet current diagnostic criteria. This is particularly useful for differentiating CNL from neutrophil leukemoid reaction, secondary to other diseases (multiple myeloma or monoclonal gammopathy of undetermined significance, in particular). CNL is considered a slowly progressing disease, but survival varies greatly. The coexistence of an ASXL1 mutation may be associated with a poorer prognosis.
A 69-year-old man was referred for unexplained leukocytosis, discovered 4 months earlier. Clinical examination revealed splenomegaly, and C-reactive protein was normal. The blood count showed anemia (hemoglobin, 96 g/L) and confirmed leukocytosis (white blood cell count, 81 × 109/L), with 69.7 × 109/L (relative value 86%) neutrophils. Toxic granulations (panel A; original magnification ×1000, May-Grünwald-Giemsa stain) and Döhle bodies (arrows, panel B; original magnification ×1000, May-Grünwald-Giemsa stain), commonly found in reactive conditions, were observed. Some neutrophil precursors (5.7 × 109/L, relative value 7%) and a slight monocytosis (1.6 × 109/L, relative value 2%) were present, but no basophils were observed. BCR-ABL1 fusion gene and JAK2, CALR, and MPL mutations were absent. Next-generation sequencing revealed CSF3R T618I, SETBP1 D868N, and ASXL1 L775X mutations. These results converged to point to a diagnosis of chronic neutrophilic leukemia (CNL).
CNL is a rare Philadelphia-negative myeloproliferative neoplasm whose true incidence is unknown. The close association between activating mutations of the CSF3R gene and CNL has recently refined its diagnosis. Therefore, with regard to >200 previously described cases, only some would meet current diagnostic criteria. This is particularly useful for differentiating CNL from neutrophil leukemoid reaction, secondary to other diseases (multiple myeloma or monoclonal gammopathy of undetermined significance, in particular). CNL is considered a slowly progressing disease, but survival varies greatly. The coexistence of an ASXL1 mutation may be associated with a poorer prognosis.
For additional images, visit the ASH Image Bank, a reference and teaching tool that is continually updated with new atlas and case study images. For more information, visit http://imagebank.hematology.org.